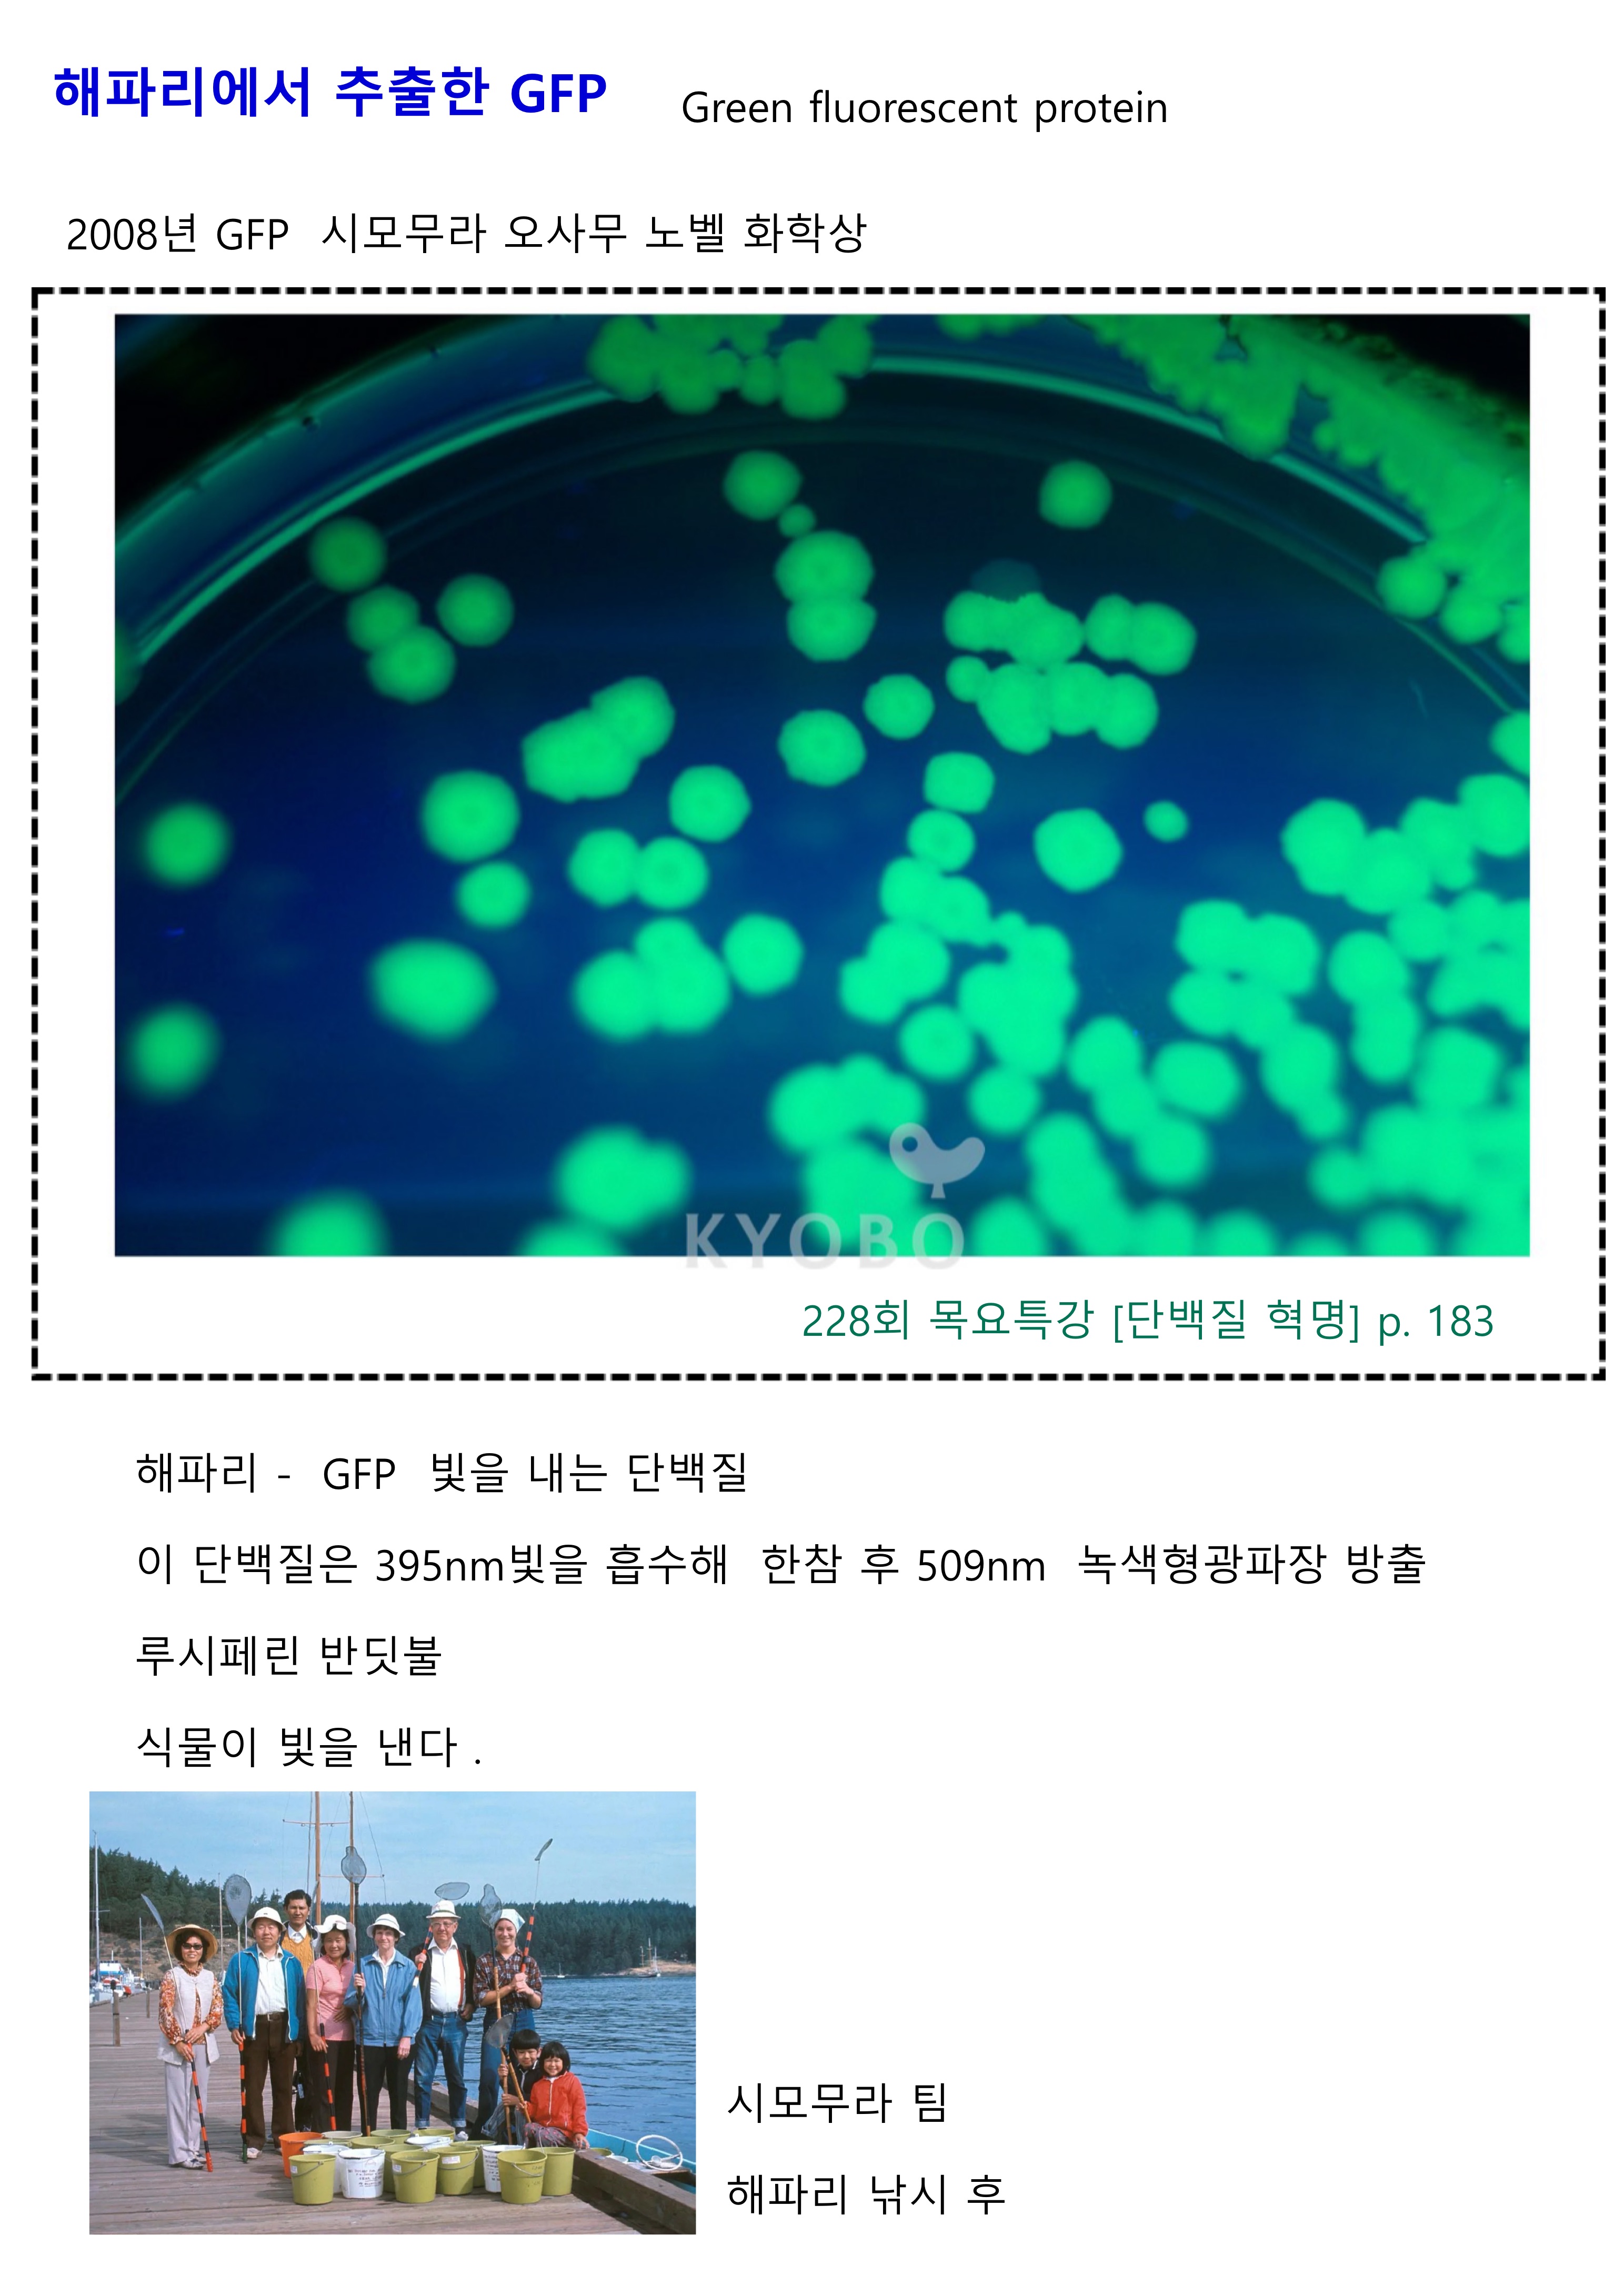

수업후기

- KakaoTalk_20251205_215738934.jpg (1.04MB)(2)
- KakaoTalk_20251205_215738934_01.jpg (365.6KB)(2)
- KakaoTalk_20251205_215738934_03.jpg (851.0KB)(2)
- KakaoTalk_20251205_215738934_04.jpg (643.1KB)(3)
- KakaoTalk_20251205_215738934_05.jpg (607.1KB)(3)
- KakaoTalk_20251205_215738934_06.jpg (931.2KB)(3)
- KakaoTalk_20251205_215738934_07.jpg (815.4KB)(2)
- KakaoTalk_20251205_215738934_08.jpg (934.3KB)(2)
- KakaoTalk_20251205_215738934_09.jpg (704.7KB)(2)
- KakaoTalk_20251205_215738934_10.jpg (724.1KB)(3)
- KakaoTalk_20251205_215738934_11.jpg (800.3KB)(2)
- KakaoTalk_20251205_215738934_12.jpg (1.03MB)(2)
- KakaoTalk_20251205_215738934_13.jpg (723.9KB)(2)
- KakaoTalk_20251205_215738934_14.jpg (827.5KB)(2)
- KakaoTalk_20251205_215738934_15.jpg (780.1KB)(3)
- KakaoTalk_20251205_215738934_16.jpg (1.05MB)(2)
- KakaoTalk_20251205_215738934_17.jpg (1.13MB)(2)
- KakaoTalk_20251205_215738934_18.jpg (518.2KB)(2)
- KakaoTalk_20251205_215738934_19.jpg (731.3KB)(2)
- KakaoTalk_20251205_215738934_20.jpg (655.8KB)(2)
- KakaoTalk_20251205_215738934_21.jpg (965.7KB)(2)
- KakaoTalk_20251205_215738934_22.jpg (505.3KB)(2)
- KakaoTalk_20251205_215738934_23.jpg (677.2KB)(2)
- KakaoTalk_20251205_215738934_24.jpg (777.2KB)(2)
- KakaoTalk_20251205_215738934_26.jpg (837.5KB)(2)
- KakaoTalk_20251205_215738934_27.jpg (399.8KB)(2)
- KakaoTalk_20251205_215738934_28.jpg (829.7KB)(2)
- KakaoTalk_20251205_215738934_29.jpg (643.6KB)(3)
- KakaoTalk_20251205_220000140.jpg (627.2KB)(2)
- KakaoTalk_20251205_220000140_01.jpg (981.7KB)(3)
- KakaoTalk_20251205_220000140_02.jpg (707.3KB)(2)
- KakaoTalk_20251205_220000140_03.jpg (534.5KB)(2)
- KakaoTalk_20251205_220000140_04.jpg (704.6KB)(2)
- KakaoTalk_20251205_220000140_05.jpg (717.5KB)(3)
- KakaoTalk_20251205_220000140_06.jpg (735.6KB)(2)
- KakaoTalk_20251205_220000140_07.jpg (732.0KB)(2)
- KakaoTalk_20251205_220000140_08.jpg (1006.7KB)(3)
- KakaoTalk_20251205_220000140_09.jpg (525.5KB)(2)
- KakaoTalk_20251205_220000140_10.jpg (956.4KB)(2)
- KakaoTalk_20251205_220000140_11.jpg (1021.0KB)(2)
- KakaoTalk_20251205_220000140_12.jpg (826.3KB)(2)
- KakaoTalk_20251205_220000140_13.jpg (750.1KB)(2)
- KakaoTalk_20251205_220000140_14.jpg (936.3KB)(2)
- KakaoTalk_20251205_220000140_15.jpg (722.2KB)(2)
- KakaoTalk_20251205_220000140_16.jpg (665.5KB)(2)
- KakaoTalk_20251205_220000140_17.jpg (538.4KB)(2)
- KakaoTalk_20251205_220000140_18.jpg (916.4KB)(2)
- KakaoTalk_20251205_220000140_19.jpg (804.7KB)(2)
- KakaoTalk_20251206_101612344.jpg (927.6KB)(0)
- KakaoTalk_20251206_121221912.jpg (771.2KB)(1)

빠르게 정리해서 올려 주셨네요.
정말 수고 많으셨습니다.
늘 감사드립니다.^^